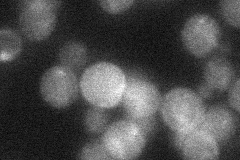
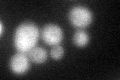

View description
High-affinity plasma membrane H+-biotin (vitamin H) symporter; mutation results in fatty acid auxotrophy; 12 transmembrane domain containing major facilitator subfamily member; mRNA levels negatively regulated by iron deprivation and biotin
Localization:
Intensity:
Fold change:
Significance:
-
C’ GFP library in SD

cell periphery42.22 -
N' NOP1pr-GFP in SD

cell periphery47.2526 -
N' TEF2pr-mCherry in SD

cell periphery,vacuole75.1211 -
N' NATIVEpr-GFP in SD
cell periphery22.7933 -
N' TEF2pr-VC and Cyto-VN in SD

below threshold29.0008 -
C’ GFP library in SD+DTT
cell periphery29.390.69No -
C’ GFP library in SD+H2O2

cell periphery35.180.83No -
C’ GFP library in Starvation Media

vacuoleN/AN/AYes -
C’ GFP library on the background of Pup2-DaMP

cell periphery -
C’ GFP library on the background of CCT mutant

cell periphery32.10940.760423No
